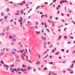
Caplacizumab may induce faster resolution of a thrombotic thrombocytopenic purpura episode

1. This systematic review identified several facilitators and barriers to health programs conducted in the African American Church, such as intrapersonal (e.g. knowledge and attitudes) and organizational (e.g. formal or informal rules) factors.
2. However, this systematic review did not find articles which identified policy as a facilitator or barrier in impacting health programs within the church.
Evidence Rating Level: 2 (Good)
The African American (AA) church has played a crucial role in promoting health programs (e.g. nutrition, HIV/AIDS, heart disease, breast cancer) for its members. Prior studies have assessed the perspectives of church leaders on health programs; however, there has yet to be an analysis exploring the facilitators and barriers in conducting adult health programs within AA churches using a socioecological perspective. As a result, the objective of the present systematic review was to identify the perception of pastors and church leaders on the facilitators and barriers in providing adult health programs using a socioecological model (SEM).
From 288 screened records, 29 studies were included from 1995 to 2019. Studies were included if they took place in the United States, if they had AA church leaders or pastors as study participants, and if they identified facilitators and barriers within the study. Studies were excluded if they took place internationally. Risk of bias in individual studies was assessed using the Mixed-Method Appraisal Tool (MMAT). The socioecological model was used to stratify facilitators and barriers found in church-based health promotion programs and interventions.
Results demonstrated that for disease or behavior-specific health programs, facilitators and barriers were primarily related to intrapersonal and organizational factors. With respect to health promotion, facilitators and barriers were primarily organizational. Furthermore, no articles identified policy as a facilitator or barrier in impacting health programs within the church. However, the present study was limited by the inclusion of only 4 databases. Nonetheless, the results demonstrated that evidence is lacking with respect to policy as a factor influencing health programs which could inform further research on this topic.
Click to read the study in Journal of Religion and Health
Image: PD
©2022 2 Minute Medicine, Inc. All rights reserved. No works may be reproduced without expressed written consent from 2 Minute Medicine, Inc. Inquire about licensing here. No article should be construed as medical advice and is not intended as such by the authors or by 2 Minute Medicine, Inc.